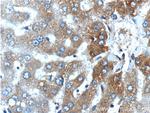
CYP1A2 Antibody in Immunohistochemistry (Paraffin) (IHC (P))

Search
Proteintech
CYP1A2 Polyclonal Antibody
{{$productOrderCtrl.translations['antibody.pdp.commerceCard.promotion.promotions']}}
{{$productOrderCtrl.translations['antibody.pdp.commerceCard.promotion.viewpromo']}}
{{$productOrderCtrl.translations['antibody.pdp.commerceCard.promotion.promocode']}}: {{promo.promoCode}} {{promo.promoTitle}} {{promo.promoDescription}}. {{$productOrderCtrl.translations['antibody.pdp.commerceCard.promotion.learnmore']}}
产品信息
19936-1-AP
种属反应
已发表种属
宿主/亚型
分类
类型
抗原
偶联物
形式
浓度
规格
纯化类型
保存液
内含物
保存条件
运输条件
产品详细信息
The antibody is specific to CYP1A2.
靶标信息
This gene encodes a member of the cytochrome P450 superfamily of enzymes. The cytochrome P450 proteins are monooxygenases which catalyze many reactions involved in drug metabolism and synthesis of cholesterol, steroids and other lipids. The protein encoded by this gene localizes to the endoplasmic reticulum and its expression is induced by some polycyclic aromatic hydrocarbons (PAHs), some of which are found in cigarette smoke. The enzyme's endogenous substrate is unknown; however, it is able to metabolize some PAHs to carcinogenic intermediates. Other xenobiotic substrates for this enzyme include caffeine, aflatoxin B1, and acetaminophen. The transcript from this gene contains four Alu sequences flanked by direct repeats in the 3' untranslated region.
仅用于科研。不用于诊断过程。未经明确授权不得转售。
生物信息学
蛋白别名: aromatic compound inducible; aryl hydrocarbon hydroxylase; Cholesterol 25-hydroxylase; CYP; CYPIA2; Cytochrome P(3)450; Cytochrome P-448; cytochrome P-450 peptide; Cytochrome P-450d; Cytochrome P450 1A2; Cytochrome P450 4; cytochrome P450 family 1 subfamily a polypeptide 1; Cytochrome P450 subfamily I (aromatic compound-inducible) member A2 (Q42 form d); cytochrome P450, 1a2; cytochrome P450, 1a2, aromatic compound inducible; cytochrome P450, family 1, subfamily A, polypeptide 2; cytochrome P450, subfamily I (aromatic compound-inducible), member A2 (Q42, form d); cytochrome P450, subfamily I (aromatic compound-inducible), polypeptide 2; Cytochrome P450-D; Cytochrome P450-P2; Cytochrome P450-P3; dioxin-inducible P3-450; flavoprotein-linked monooxygenase; Hydroperoxy icosatetraenoate dehydratase; microsomal monooxygenase; P(3)450; P-448; P450; P450 4; P450 form 4; P450-D; P450-P3; unnamed protein product; xenobiotic monooxygenase
基因别名: CP12; Cyp1a-2; Cyp1a1; CYP1A2; CYPD45; CYPIA2; P-450d; P3-450; P450(PA); P450-3; RATCYPD45
UniProt ID: (Human) P05177, (Mouse) P00186, (Rat) Q64588
Entrez Gene ID: (Human) 1544, (Mouse) 13077, (Rat) 24297